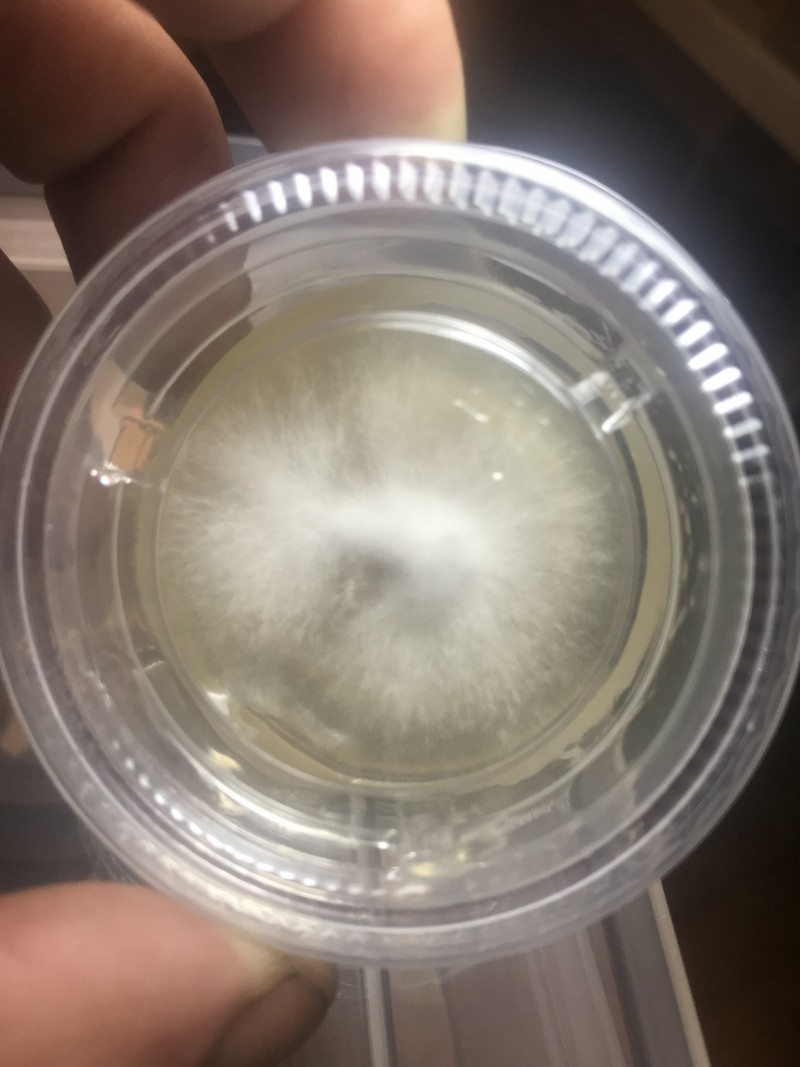
FC454776-2DDC-4931-B634-E0CDCD867EC0

FC454776-2DDC-4931-B634-E0CDCD867EC0
#420 #cannabis #cannabisseeds #cannabiscommunity #stonerfam #stoned #thc #cbd #growyourown #growweed #stoner #buds #dank #stickyicky #marijuana #gr420 #indoorgrow #budporn #hydroponics #soilgrow www.growroom420.com
- Wizard
- Registered User
- Posts: 5902
- Joined: Thu Jun 14, 2018 10:43 pm
- Status: Offline
FC454776-2DDC-4931-B634-E0CDCD867EC0
No comments yet




